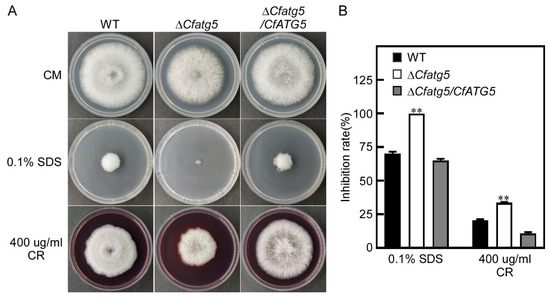

Abstract
Camellia oleifera is the native economic edible oil tree in China and anthracnose occurs commonly in its producing areas. We previously found that ubiquitin-like CfAtg8-related autophagy is essential for the pathogenicity of Colletotrichum fructicola, the major pathogen of anthracnose on C. oleifera. The aim of this study is to further elucidate the roles of autophagy in the pathogenesis of C. fructicola. Based on BLAST_P analysis and reverse genetics, we identified the central hub of another ubiquitin-like system, CfAtg5, and characterized its functions in C. fructicola. As suspected, we found that CfAtg5 is required for autophagy, both in MM-N and H2O2 induction conditions. Targeted gene deletion of CfATG5 revealed that CfAtg5 is involved in growth and conidiation. We further found that the ∆Cfatg5 mutant is defective in appressorium formation and in responses to cell wall integrity and oxidative stresses. The combined effects, together with the abolished autophagy, result in the pathogenicity defects of the ∆Cfatg5 mutant. Our study further illustrates the importance of normal autophagy in the physiology and pathogenicity of C. fructicola, and offers a potential target in the development of new anthracnose control strategies.
1. Introduction
Camellia oleifera belongs to the genus Camellia of Theaceae, which is the native economic edible oil tree in China and one of the four major woody oil trees in the world [1]. Benefiting from the high monounsaturated fatty acid of C. oleifera seeds, the oil extracted from its seeds has proved to be valuable for human health and appears in Chinese recipes [2,3]. In the United States, Japan, and France, it has also been profitable to the cosmetics industry [4]. China plans to cover more than 60,000 square kilometers of growing areas for C. oleifera in 2025, but it is still difficult to satisfy the consumption demands of tea oil. One of the major limiting factors is the outbreaks of diseases and pests in C. oleifera.
Anthracnose is the most devastating disease on C. oleifera, causing serious losses annually [5]. The fruits, leaves, and stems of C. oleifera all are susceptible to anthracnose, causing C. oleifera organs to wilt or fall off. Crucially, the oil content of diseased seeds is less than half of that of healthy seeds. Colletotrichum spp. are the casual agents of anthracnose and cause anthracnose spots and blights on almost every crop, ranking Colletotrichum spp. in the top 10 fungal pathogens in molecular plant pathology [6,7,8,9]. Generally, Colletotrichum spp. contain at least 190 recognized species and lots of cryptic species, many of which act as model plant pathosystems for biochemical and genetic studies [10,11,12,13].
For a long time, Colletotrichum gloeosporioides species complex (CGSC) has been considered to be the casual pathogen of anthracnose on C. oleifera. We previously revealed that there are at least five casual pathogens of anthracnose on C. oleifera, including C. fructicola, C. gloeosporioides, C. camelliae, C. siamense, and C. karstii [5]. Among them, C. fructicola is the major one, showing the highest pathogenicity and widest distribution [5]. In our ongoing efforts to explore the molecular mechanisms of anthracnose, we also recently identified that several virulence-related genes, including CfSnf1, CfGcn5, CfVam7, and CfSnt2 are essential for the pathogenicity of C. fructicola [14,15,16,17], but its molecular pathogenesis still remains largely elusive.
In the past 20 years, an increasing line of evidence has revealed that autophagy is pivotal for the pathogenesis of phytopathogens [18,19,20,21,22]. Autophagy is a conserved process for the degradation and recycling of proteins and organelles in the lysosome/vacuole to satisfy energy demands [23,24,25]. Multiple autophagy-related (Atg) proteins precisely mediate this process and half of the Atg proteins participate in the two ubiquitin-like conjugation systems [26,27], which is a remarkable finding in autophagy [28]. Atg8-PE and Atg12-Atg5-Atg16 systems are the two ubiquitin-like conjugation systems, respectively, and both of them are key to autophagy [29,30,31,32]. We previously found that CfAtg8 is necessary for the pathogenicity of C. fructicola, revealing the essential roles of autophagy in the pathogenesis Colletotrichum spp. [14,15], but how the Atg12-Atg5-Atg16 system functions in C. fructicola is not clear.
The Atg12-Atg5-Atg16 system regulates autophagy via protein phosphorylation and plays an important role in the formation of autophagosomes [33,34,35]. Atg5 functions as the central hub of Atg12-Atg5-Atg16 system, which first covalently conjugates with Atg12 and then binds with Atg16 to form the complex, functioning in selective and non-selective autophagy [31,36,37]. In Saccharomyces cerevisiae, Atg5 is essential to accumulating autophagosomes in vacuoles when grown on a starvation medium containing phenylmethylsulfonyl fluoride (PMSF), thus surviving the yeast in nutrient starving conditions [38]. The homologs of Atg5 protein in some phytopathogens, namely, Fusarium graminearum, Magnaporthe oryzae, and Harpophora oryzae, have also showed essential roles in autophagy and pathogenicity [39,40,41]. However, Atg5 proteins showed distinct roles in growth and conidiation. Atg5 proteins in Trichoderma reesei, F. graminearum, and M. oryzae positively regulate conidiation, whereas H. oryzae Atg5 has a negative role; similarly, T. reesei and M. oryzae Atg5 proteins are independent of growth on a completed medium, whereas Atg5 proteins in F. graminearum and T. reesei show positive and negative functions [36,39,40,41], respectively. This raises the questions of how this is different and how CfAtg5 functions in C. fructicola.
In the present study, we identified CfAtg5 in C. fructicola and elucidated its pleiotropic functions in growth, conidiation, appressorium formation, stress responses, autophagy, and pathogenicity.
2. Materials and Methods
2.1. Strains and Conditions
In this study, the wild-type strain was CFLH16. All strains were cultured at 28 °C in darkness on a complete medium (CM: 10 g D-glucose, 2 g peptone, 1 g casamino acid, 1 g yeast extract, 1 mL vitamin solution (0.01 g biotin, 0.01 g pyridoxine, 0.01 g thiamine, 0.01 g riboflavin, 0.01 g p-aminobenzoic acid, and 0.01 g nicotinic acid in 1 L ddH2O), 1 mL trace elements (1.1 g H3BO3, 2.2 g ZnSO4·7H2O, 0.5 g FeSO4·7H2O, 0.5 g MnCl2·4H2O, 0.17 g CoCl2·6H2O, 0.15 g Na2MnO4·2H2O, 0.16 g CuSO4·5H2O, 5 g Na4EDTA in 100 mL ddH2O, pH5.8), 50 mL 20× nitrate salts (120 g NaNO3, 10.4 g MgSO4·7H2O, 10.4 g KCl, 30.4 g KH2PO4 in 1 L ddH2O)) or a minimal medium (MM: 6 g NaNO3, 1.52 g KH2PO4, 0.52 g KCl, 10 g Glucose, 0.01 g VB1, 0.152 g MgSO4·7H2O, 1 mL 1000× trace elements, and 15 g agar in 1 L ddH2O), while MM-N media do not contain the NaNO3. The liquid CM was used to prepare mycelia for DNA and protein extraction.
2.2. Phylogenetic Tree Construction and Domain Prediction
The Atg5 protein in T. reesei, F. graminearum, Neurospora crassa, M. oryzae, C. gloeosporioides, Aspergillus oryzae, Phaeosphaeria nodorum, and S. cerevisiae were obtained from the NCBI database. Then the phylogenetic tree was constructed by Mega 7.0 software with the Neighbor-Joining method. The domain prediction of CfAtg5 was performed by SMART website.
2.3. Gene Deletion and Complementation
Targeted CfATG5 gene deletion was executed by standard one-step strategy, as in our previous descriptions [14,16,17]. Initially, the two ~1.0 kb flanking sequences of CfATG5 overlapped the two sides of HPH, respectively. Then, the ~3.4 kb fragments were transformed into the protoplasts of WT for gene knockout. The ∆Cfatg5 mutant was isolated and confirmed from the hygromycin-resistant colonies. Finally, the fragment of the CfATG5 native promoter and the gene coding sequence were amplified by PCR (polymerase chain reaction) with primers (Table S1) and co-transformed with XhoI-digested pYF11 (bleomycin resistance) into yeast strain XK1-25 and Escherichia coli TreliefTM 5α (TsingKe Biological Technology Co., Ltd., Beijing, China). After sequencing, the complemented vector was introduced into the mutant to complement the mutant strain.
2.4. Growth, Conidiation and Appressoria Formation Assays
Small agar blocks of WT, ∆Cfatg5, and ∆Cfatg5/CfATG5 were cut from the edge of 3-day-old cultures and were cultured on CM and MM media for 3 days in the dark at 28 °C. Then, the diameters of strains were measured and photographed as in our previous description [16]. In the conidia production experiments, the strains above were cultured on liquid CM in a shaker for 48 h, and the conidia were observed after filtering with three layers of filter paper. For appressoria formation assays, the collected conidia were dropped onto hydrophobic glass slides and incubated at 28 °C; then, they were observed and photographed under the microscope (ZEISS, Axio Observer. A1) at 16 h and 24 h.
2.5. Stress Response and Cellophane Penetration Assays
For stress response assays, the strains of WT, ∆Cfatg5, and ∆Cfatg5/CfATG5 were cultured on CM and CM medium plus with cell wall integrity stress (400 µg/mL CR and 0.1% SDS) and oxidative stress (10 mM H2O2) for 3 days, the colony diameters were measured, and the inhibition rates were statistically analyzed. For cellophane penetration, assays were tested as in our previous description [42]. First, the above strains were inoculated on cellophane for 2 days, then the cellophane was removed and continuously cultured for 4 days, observing strains penetration conditions.
2.6. Pathogenicity Assays
The WT, ∆Cfatg5, and ∆Cfatg5/CfATG5 strains were inoculated on the edge of injured and healthy tea oil leaves in moisturizing culture at 28 °C for 2 days; then, its lesions were observed and measured. The above strains were also inoculated on wounded apples as in our previous description [17]. First, several 4-mm-diameter holes were punched evenly on the apples; then, the strains of the same diameter were inoculated onto it. Finally, the apples were cultured in an incubator for 4~5 days and the lesions were measured and statistically analyzed.
2.7. Autophagy Induction and Western Blotting Assays
The WT and ∆Cfatg5 strains that transformed the GFP-CfATG8 gene were cultured on liquid CM medium for 36 h, then the mycelia were washed with ddH2O and collected, followed by treatment with MM-N or 10 mM H2O2 for 4 h or 8 h. The autophagosomes and GFP signals were observed under fluorescence microscope (ZEISS, Axio Observer. A1) and statistically analyzed. The western blotting analyses were carried out according to our previous description [14]. First, the mycelia of the above strains, treated with CM and MM-N, were frozen in liquid nitrogen before protein extraction. Then, the frozen mycelia were ground into a fine powder in liquid nitrogen and re-suspended in 1 mL lysis buffer (EpiZyme, PC101) with 10 ul proteinase inhibitor cocktail (EpiZyme, GRF101). For protein lysing, the lysates were placed in the ice for 30 min, re-suspending with a vortex-genie once every 10 min, followed by centrifugation at 12,000 rpm for 20 min at 4 °C, and the supernatant proteins were harvested. The proteins were analyzed by 10% SDS-PAGE and western blotting. The primary antibodies of protein analysis by western blotting were anti-GFP (rabbit, 1:5000, Abways, AB0045) and anti-β-tubulin (mouse, 10,000, Engibody, AT0003), and the second antibodies were HRP-labeled goat anti-rabbit lgG (H+L) (1:10,000, Abways, AB0101) and HRP-labeled goat anti-mouse lgG (H+L) (1:20,000, HUABIO, HA1006). After that, the proteins were detected by Omni-ECL Femto Light chemiluminescence kit (EpiZyme, SQ201) and analyzed by ImageJ.
2.8. Accession Number
The sequence data of this research can be acquired in the GenBank database (https://www.ncbi.nlm.nih.gov/genbank/, (accessed on 20 February 2023)) with the following accession numbers: MK622895 (CfAtg8), ACL13625.1 (TrAtg5), XP_011318981.1 (FgAtg5), XP_959205.3 (NcAtg5), XP_003709895.1 (MoAtg5), XP_031889187.1 (CfAtg5), XP_045267928.1 (CgAtg5), XP_023091599.1 (AoAtg5), KAH3985998.1 (PnAtg5), and NP_015176.1 (ScAtg5).
2.9. Statistical Analysis
Each result was showed as the mean ± SD of three replicates. The significance of differences between samples were analyzed by ANOVA (Analysis of Variance) with Duncan’s new multiple range test. The level of significance was set at as p < 0.01.
3. Results
3.1. The Phylogenetic Tree Analysis and Domain Prediction of CfAtg5
We identified CfAtg5 in the C. fructicola database by using ScAtg5 amino acid sequence of S. cerevisiae as a bait through a BLAST_P search on the NCBI website (https://www.ncbi.nlm.nih.gov/, (accessed on 20 February 2023), and the phylogenetic tree of CfAtg5 was constructed by Neighbor-Joining Algorithm of Mega 7.0 software. The result revealed that CfAtg5 is a putative protein of 277 amino acids and has the most similar homology to that of C. gloeosporioides and the most distant from that of S. cerevisiae (Figure 1A). The domain prediction by SMART website (http://smart.embl-heidelberg.de/, (accessed on 21 February 2023) suggested that CfAtg5 contains an APG5 domain consisting of 63~275 amino acids (Figure 1B).

Figure 1.
Phylogenetic analysis of Atg5 protein in fungi and domain prediction of CfAtg5. (A) The Atg5 proteins from diverse fungi were aligned using the CLUSTAL_W, and the Neighbor-joining tree was constructed by Mega 7.0 with 1000 bootstrap replicates. The scale is 0.2. The organisms and GenBank accession numbers are shown as follows: TrAtg5 (T. reesei, ACL13625.1); FgAtg5 (F. graminearum, XP_011318981.1); NcAtg5 (Neurospora crassa, XP_959205.3); MoAtg5 (M. oryzae, XP_003709895.1); CfAtg5 (C. fructicola, XP_031889187.1); CgAtg5 (C. gloeosporioides, XP_045267928.1); AoAtg5 (A. oryzae, XP_023091599.1); PnAtg5 (Phaeosphaeria nodorum, KAH3985998.1); ScAtg5 (S. cerevisiae, NP_015176.1). (B) The domain prediction of CfAtg5. The gray quadrilateral (63∼275 amino acids) indicates the APG5 domain.
3.2. Targeted Deletion of CfATG5 Gene in C. fructicola
For characterizing the functions of CfAtg5 in C. fructicola, the coding region of the CfATG5 gene was substituted by the HPH gene with the homologous recombination principle and PEG-mediated method as in our previous descriptions [15,17,43] (Figure S1A). One ∆Cfatg5 mutant was isolated and confirmed from the hygromycin-resistant colonies (Figure S1B). Moreover, the wild-type CfATG5 gene was re-introduced into the mutant that restored all defects.
3.3. The CfAtg5 Positively Regulates Autophagy Process
In order to clarify the relationship between CfAtg5 and autophagy process, GFP-ATG8 gene, the most commonly used autophagosome reliable marker [14,15,22,44,45], was transformed into WT (CFLH16) and ∆Cfatg5 mutant. After being treated with MM-N for 4 h, the autophagosomes that produced by WT all entered to vacuoles for degradation, but ∆Cfatg5 did not (Figure 2A). We further detected autophagic flux by GFP-Atg8 proteolysis assays through western blotting. When induced in MM-N for 4 h, the WT showed significantly higher free GFP than no induction, whereas ∆Cfatg5 showed no GFP both in induction for 4 h and in no induction conditions (Figure 2B), suggesting the higher autophagy level in WT and the abolished autophagy in the ∆Cfatg5 mutant. These results showed that CfAtg5 plays a positive essential role in autophagy.

Figure 2.
CfAtg5 positively regulates autophagy. (A) Micrographs of GFP-Atg8 labeled autophagosomes in the WT and ∆Cfatg5 mutant at 0 h and 4 h. (B) Western blotting analysis of GFP-CfAtg8 proteolysis. For GFP-CfAtg8 proteolysis, the upper lanes point to the full GFP-CfAtg8 (46 kDa) and the lower lanes point to the free GFP (26 kDa); for β-tubulin, the lanes point to the β-tubulin (55 kDa).
3.4. The CfAtg5 Is Important for Growth
To investigate whether CfAtg5 participates in regulating growth of C. fructicola, the strains of WT, ∆Cfatg5 mutant and ∆Cfatg5/CfATG5 were inoculated on complete medium (CM) and minimal medium (MM) plates for 3 days; then, the diameters of strains were measured and analyzed. The results showed that the colony diameters of ∆Cfatg5 were significantly smaller than those of the WT and ∆Cfatg5/CfATG5 strains (Figure 3A,B). Meanwhile, we further found that the aerial hyphal growth rate of ∆Cfatg5 was reduced compared to that of the WT and ∆Cfatg5/CfATG5 strains (Figure 3C). The results showed that CfAtg5 is involved in the vegetable growth of C. fructicola.

Figure 3.
CfAtg5 is important for growth. (A) The growth of WT, ∆Cfatg5 mutant and ∆Cfatg5/CfATG5 in CM and MM plates for 3 days. (B) The diameters of the above strains were measured and statistically analyzed. The standard deviation (SD) of the three replicates is represented by error bars. Asterisks represent the significant difference (p < 0.01). (C) Aerial hyphae growth of strains was observed. The above strains were cultured on CM plates for 3 days and the colony side view was shown.
3.5. The CfAtg5 Is Required for the Full Pathogenicity of C. fructicola
To characterize the roles of CfAtg5 in pathogenicity, the WT, ∆Cfatg5, and ∆Cfatg5/CfATG5 strains were inoculated on the injured and healthy leaves of C. oleifera. The results showed that the diseased areas of the ∆Cfatg5 mutant were significantly smaller than those of the WT and ∆Cfatg5/CfATG5 strains on injured leaves and that the ∆Cfatg5 mutant could not develop lesions on healthy leaves, in contrast to the typical lesions caused by the WT and ∆Cfatg5/CfATG5 strains (Figure 4A,B). In order to study whether the role of CfAtg5 in pathogenicity is specific for C. oleifera, we inoculated the above strains on injured apples and found that ∆Cfatg5 could develop lesions and that the lesions caused by ∆Cfatg5 were far smaller than those of the WT and ∆Cfatg5/CfATG5 strains (Figure 4C,D). The results indicated that CfAtg5 is essential for the full pathogenicity of C. fructicola.

Figure 4.
CfAtg5 is required for the full pathogenicity. (A) The WT, ∆Cfatg5, and ∆Cfatg5/CfATG5 strains were inoculated on wounded and healthy tea oil leaves. (B) Statistical analysis of disease areas of strains on wounded and healthy tea oil leaves. (C) The strains were inoculated on wounded apples. (D) Statistical analysis of disease areas on apples. CK: comparable control. Asterisks represent the significant difference (** p < 0.01, * p < 0.5).
3.6. The CfAtg5 Mediates the Appressoria Formation and Conidiation of C. fructicola
Appressoria formation is a key step for the Colletotrichum to infect hosts [46,47,48]. In order to explore the potential mechanism of the pathogenicity defects of ∆Cfatg5, we present the appressoria formation of the WT, ∆Cfatg5, and ∆Cfatg5/CfATG5 strains, which were cultured on a hydrophobic glass slide, observed, and photographed at 16 h and 24 h. The results showed that the appressoria formed by ∆Cfatg5 were both far less than those formed by the WT and ∆Cfatg5/CfATG5 strains at 16 h and 24 h (Figure 5A,B). Meanwhile, we found that the conidia produced by ∆Cfatg5 were significantly fewer than those produced by the WT and ∆Cfatg5/CfATG5 strains (Figure 5C). The results revealed that CfAtg5 mediates the appressoria formation and conidiation of C. fructicola.

Figure 5.
CfAtg5 mediates appressoria formation and conidiation. (A) The conidia of the WT, ∆Cfatg5, and ∆Cfatg5/CfATG5 strains were moisture cultured on hydrophobic glass for 16 h and 24 h, and appressoria formation was observed. (B) Appressoria formation was statistically analyzed. (C) Statistical analysis of conidia. ** represent the significant difference (p < 0.01).
In addition, we found that WT, ∆Cfatg5, and ∆Cfatg5/CfATG5 all penetrated the cellophane under the inoculation of both conidia and mycelia (Figure S2A,B). This result suggested that the epidermal structure of C. oleifera leaves is more complex than that of cellophane, resulting in the non-penetration on tea oil leaves but the penetration on cellophane of the ∆Cfatg5 mutant.
3.7. The CfAtg5 Is Involved in the Response to Cell Wall Integrity Stress
Cell wall integrity is crucial to the pathogenicity of fungi because it is the first barrier between fungi and the outside world and it plays a role in defending external stress [49,50]. In order to analyze the roles of CfAtg5 in cell wall integrity stress, the strains of WT, ∆Cfatg5, and ∆Cfatg5/CfATG5 were inoculated on CM and CM fortified with 400 µg/mL Congo red (CR) and 0.1% sodium dodecyl sulfate (SDS). The results showed that the inhibition rates of ∆Cfatg5 were both significantly higher than those of WT and ∆Cfatg5/CfATG5 (Figure 6A,B), which indicates that CfAtg5 is involved in the response to cell wall integrity stress.
Figure 6.
CfAtg5 is involved in the response to cell wall integrity stress. (A) The strains of the WT, ∆Cfatg5, and ∆Cfatg5/CfATG5 were cultured on CM and CM plus 400 µg/mL CR and 0.1% SDS for 3 days. (B) The inhibition rate of strains to cell wall integrity stress was statistically analyzed against untreated control. ** represent the significant difference (p < 0.01).
3.8. The CfAtg5 Participates in Responding to Oxidative Stress
The reactive oxygen species (ROS) is a common defense in plant–pathogen interactions, and pathogens must counteract host-derived ROS to successfully infect plants [43,51]. Therefore, we used H2O2, the major messenger for deliver oxidative signals [52], to simulate host-derived ROS stress. When the WT, ∆Cfatg5, and ∆Cfatg5/CfATG5 strains were treated with 10 mM H2O2, the inhibition rate of ∆Cfatg5 was significantly higher than that of the WT and ∆Cfatg5/CfATG5 strains (Figure 7A,B). In addition, cells will induce autophagy to limit ROS production when faced with continuous oxidative stress [53], so we further used CM plus with 10 mM H2O2 as an inducer to verify this. The results showed that the autophagosomes produced by WT entered vacuoles for degradation at 4 h, but the autophagosomes produced by ∆Cfatg5 did not enter vacuoles until 8 h (Figure 7C). These results revealed that CfAtg5 participates in the response to oxidative stress and further showed that the ∆Cfatg5 mutant can block the autophagy process.

Figure 7.
CfAtg5 participates in the response to oxidative stress. (A) The strains of the WT, ∆Cfatg5, and ∆Cfatg5/CfATG5 were cultured on CM and CM plus with 10 mM H2O2 for 3 days. (B) The inhibition rate of strains was statistically analyzed against untreated control. (C) The WT and ∆Cfatg5 mutant strains, transformed with GFP-CfAtg8, were incubated in CM added 10 mM H2O2 for 4 h and 8 h. Then the strains were observed under a microscope. ** represent the significant difference (p < 0.01).
4. Discussion
In this study, we identified an autophagy-related protein CfAtg5 in C. fructicola and analyzed its biological functions. We found that CfAtg5 is essential for the autophagy process and is involved in the growth, conidiation, appressoria formation, stress responses, and pathogenicity of C. fructicola.
We found that deletion of CfATG5 causes a decreased growth rate, revealing the positive role of CfAtg5 in growth, which is similar to the function of the homologs of Atg5 in F. graminearum and Homo sapiens [40,54]. However, in M. oryzae and T. reseei, the growth rates of targeted ATG5 gene deletion mutants showed no significant difference to wild-type in CM conditions, but decreased in nutrient starvation conditions [36,39]. Additionally, the deletion of ATG5 could increase the growth rate in H. oryzae [41]. Thus, we hypothesized that Atg5 proteins show distinct functions in different organisms. The conidiation assays further confirmed this hypothesis. The CfAtg5 positively regulates conidiation, which is consistent with the studies in Trichoderma reesei, F. graminearum, and M. oryzae [36,39,40], whereas H. oryzae Atg5 demonstrates a negative role in conidiation [41]. These diversities in growth and conidiation reflect distinct mechanisms of Atg5 proteins during growth and asexual development in different fungi.
Autophagy is a conserved biological process in eukaryotic cells [23]. As expected, we found that autophagy is blocked in the ∆Cfatg5 mutant, both in MM-N- and H2O2-induced conditions, which is consistent with the studies in all other tested phytopathogens [36,39,40,41]. Our results further reflect the conservation of Atg5 in autophagy. Recently, we appraised the importance of autophagy in the pathogenesis of C. fructicola [14,15]. The abolished autophagy in the ∆Cfatg5 mutant might foretell its defects with respect to pathogenicity.
Indeed, we found that the ∆Cfatg5 mutant cannot cause disease spots on healthy tea oil leaves and causes decreased disease spots on wounded leaves and apples. We reasoned that the pathogenicity defects of the ΔCfatg5 mutant were directly due to the decreased appressoria formation rate, which is essential for Colletotrichum to infect host plants [46,47,48]. The ΔCfatg5 mutant still forms some appressoria, which is likely to be non-functional for penetration, according non-pathogenicity to the ΔCfatg5 mutant on healthy tea oil leaves. Moreover, the reduced pathogenicity of the ΔCfatg5 mutant on wounded leaves and apples further reveals its defects with respect to invasive hyphae growth in the host cells. In addition, we found that the ΔCfatg5 mutant is more sensitive to cell wall integrity stress and oxidative stress. Considering that the cell wall is the first barrier between fungi and the host, and that pathogens must counteract host-derived ROS to successfully infect plants [43,49,50,51], we concluded that the defects of the ΔCfatg5 mutant in the responses to these two stresses might also cause its pathogenicity defects. Intriguingly, we found that H2O2 induces autophagy in phytopathogens for the first time. It might be very interesting to investigate whether phytopathogens counteract host-derived ROS via autophagy; further studies are highly warranted.
In summary, our study not only indicates the roles of CfAtg5 in autophagy but also illustrates the pleiotropic functions of CfAtg5 in the growth, conidiation, appressorium formation, stress responses, and pathogenicity of C. fructicola. Therefore, we indicate that CfAtg5 is a potential fungicide target in the development of new anthracnose control strategies.
5. Conclusions
In the present study, we identified the autophagy-related protein CfAtg5 and characterized its functions in C. fructicola. According to our results, CfAtg5 is important for growth and conidiation in C. fructicola. CfAtg5 also functions as a regulator for cell wall integrity and oxidative stresses responses. Moreover, we found that CfAtg5 is involved in appressoria formation. Most importantly, we revealed that CfAtg5 is required for autophagy, both in MM-N and H2O2 induction conditions. These combined pleiotropic functions result in CfAtg5’s essential roles in the pathogenicity of C. fructicola. This is the first study to characterize the ubiquitin-like Atg12-Atg5-Atg16 system in Colletotrichum, which further illustrates the importance of normal autophagy in the physiology and pathogenicity of C. fructicola. This study also offers a potential target in the development of new anthracnose control strategies.
Supplementary Materials
The following supporting information can be downloaded at: https://www.mdpi.com/article/10.3390/agronomy13051237/s1, Figure S1: Generation of the CfATG5 gene deletion mutant in C. fructicola; Figure S2: CfAtg5 does not affect the penetration ability; Table S1. The primers used in this study.
Author Contributions
Conceptualization, S.Z. and H.L.; Methodology, Y.C. and S.Z.; Investigation, Y.C., J.J., Y.L., H.J., L.L. and Q.C.; Writing—Original Draft, Y.C. and S.Z.; Writing—Review and Editing, S.Z. and H.L.; Funding Acquisition, S.Z.; Resources, S.Z. and H.L.; Supervision, S.Z. and H.L. All authors have read and agreed to the published version of the manuscript.
Funding
This research was funded by National Natural Science Foundation of China (32001317).
Institutional Review Board Statement
Not applicable.
Informed Consent Statement
Not applicable.
Data Availability Statement
All data supporting the findings of this study are available within the paper and within its supplementary materials published online.
Conflicts of Interest
The authors declare no conflict of interest.
Abbreviations
PMSF (phenylmethylsulfonyl fluoride); PCR (polymerase chain reaction); CR (Congo red); SDS (sodium dodecyl sulfate); ROS (reactive oxygen species); complete medium (CM); minimal medium (MM).
References
- Chen, Y.Z.; Wang, B.M.; Chen, J.J.; Wang, X.N.; Wang, R.; Peng, S.F.; Chen, L.S.; Ma, L.; Luo, J. Identification of Rubisco rbcL and rbcS in Camellia oleifera and their potential as molecular markers for selection of high tea oil cultivars. Front. Plant Sci. 2015, 6, 189. [Google Scholar] [CrossRef]
- Di, T.M.; Yang, S.L.; Du, F.Y.; Zhao, L.; Li, X.H.; Xia, T.; Zhang, X.F. Oleiferasaponin A(2), a Novel Saponin from Camellia oleifera Abel. Seeds, Inhibits Lipid Accumulation of HepG2 Cells Through Regulating Fatty Acid Metabolism. Molecules 2018, 23, 3296. [Google Scholar] [CrossRef]
- Feas, X.; Estevinho, L.M.; Salinero, C.; Vela, P.; Sainz, M.J.; Vazquez-Tato, M.P.; Seijas, J.A. Triacylglyceride, Antioxidant and Antimicrobial Features of Virgin Camellia oleifera, C. reticulata and C. sasanqua Oils. Molecules 2013, 18, 4573–4587. [Google Scholar] [CrossRef] [PubMed]
- Wang, X.Q.; Zeng, Q.M.; Contreras, M.D.; Wang, L.J. Profiling and quantification of phenolic compounds in Camellia seed oils: Natural tea polyphenols in vegetable oil. Food Res. Int. 2017, 102, 184–194. [Google Scholar] [CrossRef]
- Li, H.; Zhou, G.Y.; Liu, J.A.; Xu, J.P. Population Genetic Analyses of the Fungal Pathogen Colletotrichum fructicola on Tea-Oil Trees in China. PLoS ONE 2016, 11, e0156841. [Google Scholar] [CrossRef] [PubMed]
- O’Connell, R.J.; Thon, M.R.; Hacquard, S.; Amyotte, S.G.; Kleemann, J.; Torres, M.F.; Damm, U.; Buiate, E.A.; Epstein, L.; Alkan, N.; et al. Lifestyle transitions in plant pathogenic Colletotrichum fungi deciphered by genome and transcriptome analyses. Nat. Genet. 2012, 44, 1060–1065. [Google Scholar] [CrossRef]
- Dean, R.; Van Kan, J.A.L.; Pretorius, Z.A.; Hammond-Kosack, K.E.; Di Pietro, A.; Spanu, P.D.; Rudd, J.J.; Dickman, M.; Kahmann, R.; Ellis, J.; et al. The Top 10 fungal pathogens in molecular plant pathology. Mol. Plant Pathol. 2012, 13, 804. [Google Scholar] [CrossRef]
- Wu, J.Y.; Hu, S.D.; Ye, B.Y.; Hu, X.R.; Xiao, W.F.; Yu, H.; Zhang, C.Q. Diversity and Resistance to Thiophanate-Methyl of Colletotrichum spp. in Strawberry Nursery and the Development of Rapid Detection Using LAMP Method. Agronomy 2022, 12, 2815. [Google Scholar] [CrossRef]
- Monteiro, F.; Romeiras, M.M.; Barnabe, J.; Catarino, S.; Batista, D.; Sebastiana, M. Disease-Causing Agents in Cashew: A Review in a Tropical Cash Crop. Agronomy 2022, 12, 2553. [Google Scholar] [CrossRef]
- Durrant, W.E.; Dong, X. Systemic acquired resistance. Annu. Rev. Phytopathol. 2004, 42, 185–209. [Google Scholar] [CrossRef]
- Hyde, K.D.; Cai, L.; Cannon, P.F.; Crouch, J.A.; Crous, P.W.; Damm, U.; Goodwin, P.H.; Chen, H.; Johnston, P.R.; Jones, E.B.G.; et al. Colletotrichum—Names in current use. Fungal Divers 2009, 39, 147–182. [Google Scholar]
- Takahara, H.; Hacquard, S.; Kombrink, A.; Hughes, H.B.; Halder, V.; Robin, G.P.; Hiruma, K.; Neumann, U.; Shinya, T.; Kombrink, E.; et al. Colletotrichum higginsianum extracellular LysM proteins play dual roles in appressorial function and suppression of chitin-triggered plant immunity. New Phytol. 2016, 211, 1323–1337. [Google Scholar] [CrossRef] [PubMed]
- Guevara-Suarez, M.; Cardenas, M.; Jimenez, P.; Afanador-Kafuri, L.; Restrepo, S. Colletotrichum Species Complexes Associated with Crops in Northern South America: A Review. Agronomy 2022, 12, 548. [Google Scholar] [CrossRef]
- Zhang, S.; Guo, Y.; Li, S.; Li, H. Histone Acetyltransferase CfGcn5-Mediated Autophagy Governs the Pathogenicity of Colletotrichum fructicola. mBio 2022, 13, e0195622. [Google Scholar] [CrossRef]
- Guo, Y.; Chen, Z.; Li, H.; Zhang, S. The CfSnt2-dependent deacetylation of histone H3 mediates autophagy and pathogenicity of Colletotrichum fructicola. J. Fungi 2022, 8, 974. [Google Scholar] [CrossRef] [PubMed]
- Li, S.; Zhang, S.; Li, B.; Li, H. The SNARE protein CfVam7 Is required for growth, endoplasmic reticulum stress response, and pathogenicity of Colletotrichum fructicola. Front. Microbiol. 2021, 12, 736066. [Google Scholar] [CrossRef]
- Zhang, S.; Guo, Y.; Chen, S.; Li, H. The Histone Acetyltransferase CfGcn5 Regulates Growth, Development, and Pathogenicity in the Anthracnose Fungus Colletotrichum fructicola on the Tea-Oil Tree. Front. Microbiol. 2021, 12, 680415. [Google Scholar] [CrossRef] [PubMed]
- Zheng, H.W.; Miao, P.F.; Lin, X.L.; Li, L.P.; Wu, C.X.; Chen, X.M.; Abubakar, Y.S.; Norvienyeku, J.; Li, G.P.; Zhou, J.; et al. Small GTPase Rab7-mediated FgAtg9 trafficking is essential for autophagy- dependent development and pathogenicity in Fusarium graminearum. PLoS Genet 2018, 14, e1007546. [Google Scholar] [CrossRef]
- Talbot, N.J.; Kershaw, M.J. The emerging role of autophagy in plant pathogen attack and host defence. Curr. Opin. Plant Biol. 2009, 12, 444–450. [Google Scholar] [CrossRef]
- Zhu, X.M.; Li, L.; Wu, M.; Liang, S.; Shi, H.B.; Liu, X.H.; Lin, F.C. Current opinions on autophagy in pathogenicity of fungi. Virulence 2019, 10, 481–489. [Google Scholar] [CrossRef]
- Veneault-Fourrey, C.; Barooah, M.; Egan, M.; Wakley, G.; Talbot, N.J. Autophagic fungal cell death is necessary for infection by the rice blast fungus. Science 2006, 312, 580–583. [Google Scholar] [CrossRef]
- Kershaw, M.J.; Talbot, N.J. Genome-wide functional analysis reveals that infection-associated fungal autophagy is necessary for rice blast disease. Proc. Natl. Acad. Sci. USA 2009, 106, 15967–15972. [Google Scholar] [CrossRef] [PubMed]
- Ohsumi, Y. Historical landmarks of autophagy research. Cell Res. 2014, 24, 9–23. [Google Scholar] [CrossRef] [PubMed]
- Mizushima, N.; Komatsu, M. Autophagy: Renovation of cells and tissues. Cell 2011, 147, 728–741. [Google Scholar] [CrossRef]
- Seglen, P.O.; Bohley, P. Autophagy and other vacuolar protein degradation mechanisms. Experientia 1992, 48, 158–172. [Google Scholar] [CrossRef]
- Klionsky, D.J.; Cregg, J.M.; Dunn, W.A., Jr.; Emr, S.D.; Sakai, Y.; Sandoval, I.V.; Sibirny, A.; Subramani, S.; Thumm, M.; Veenhuis, M.; et al. A unified nomenclature for yeast autophagy-related genes. Dev. Cell 2003, 5, 539–545. [Google Scholar] [CrossRef]
- Klionsky, D.J. Autophagy: From phenomenology to molecular understanding in less than a decade. Nat. Rev. Mol. Cell Biol. 2007, 8, 931–937. [Google Scholar] [CrossRef]
- Ohsumi, Y. Molecular dissection of autophagy: Two ubiquitin-like systems. Nat. Rev. Mol. Cell Biol. 2001, 2, 211–216. [Google Scholar] [CrossRef] [PubMed]
- Johansen, T.; Lamark, T. Selective autophagy: ATG8 family proteins, LIR motifs and cargo receptors. J. Mol. Biol. 2020, 432, 80–103. [Google Scholar] [CrossRef]
- Nakatogawa, H. Two ubiquitin-like conjugation systems that mediate membrane formation during autophagy. Essays Biochem. 2013, 55, 39–50. [Google Scholar]
- Ichimura, Y.; Kirisako, T.; Takao, T.; Satomi, Y.; Shimonishi, Y.; Ishihara, N.; Mizushima, N.; Tanida, I.; Kominami, E.; Ohsumi, M.; et al. A ubiquitin-like system mediates protein lipidation. Nature 2000, 408, 488–492. [Google Scholar] [CrossRef] [PubMed]
- Ohsumi, Y.; Mizushima, N. Two ubiquitin-like conjugation systems essential for autophagy. Semin. Cell Dev. Biol. 2004, 15, 231–236. [Google Scholar] [CrossRef] [PubMed]
- Hanada, T.; Noda, N.N.; Satomi, Y.; Ichimura, Y.; Fujioka, Y.; Takao, T.; Inagaki, F.; Ohsumi, Y. The Atg12-Atg5 conjugate has a novel E3-like activity for protein lipidation in autophagy. J. Biol. Chem. 2007, 282, 37298–37302. [Google Scholar] [CrossRef] [PubMed]
- Fujioka, Y.; Noda, N.N.; Fujii, K.; Yoshimoto, K.; Ohsumi, Y.; Inagaki, F. In vitro reconstitution of plant Atg8 and Atg12 conjugation systems essential for autophagy. J. Biol. Chem. 2008, 283, 1921–1928. [Google Scholar] [CrossRef]
- Simon, H.U.; Friis, R. ATG5: A distinct role in the nucleus. Autophagy 2014, 10, 176–177. [Google Scholar] [CrossRef]
- Liu, X.H.; Yang, J.; He, R.L.; Lu, J.P.; Zhang, C.L.; Lu, S.L.; Lin, F.C. An autophagy gene, TrATG5, affects conidiospore differentiation in Trichoderma reesei. Res. Microbiol. 2011, 162, 756–763. [Google Scholar] [CrossRef]
- Mizushima, N.; Noda, T.; Ohsumi, Y. Apg16p is required for the function of the Apg12p–Apg5p conjugate in the yeast autophagy pathway. EMBO J. 1999, 18, 3888–3896. [Google Scholar] [CrossRef]
- Kametaka, S.; Matsuura, A.; Wada, Y.; Ohsumi, Y. Structural and functional analyses of APG5, a gene involved in autophagy in yeast. Gene 1996, 178, 139–143. [Google Scholar] [CrossRef]
- Lu, J.P.; Liu, X.H.; Feng, X.X.; Min, H.; Lin, F.C. An autophagy gene, MgATG5, is required for cell differentiation and pathogenesis in Magnaporthe oryzae. Curr. Genet. 2009, 55, 461–473. [Google Scholar] [CrossRef]
- Lv, W.; Wang, C.; Yang, N.; Que, Y.; Talbot, N.J.; Wang, Z. Genome-wide functional analysis reveals that autophagy is necessary for growth, sporulation, deoxynivalenol production and virulence in Fusarium graminearum. Sci. Rep. 2017, 7, 11062. [Google Scholar] [CrossRef]
- Liu, N.; Ning, G.A.; Liu, X.H.; Feng, X.X.; Lu, J.P.; Mao, L.J.; Su, Z.Z.; Wang, Y.; Zhang, C.L.; Lin, F.C. An autophagy gene, HoATG5, is involved in sporulation, cell wall integrity and infection of wounded barley leaves. Microbiol. Res. 2016, 192, 326–335. [Google Scholar] [CrossRef]
- Zhang, S.; Guo, Y.; Li, S.; Zhou, G.; Liu, J.; Xu, J.; Li, H. Functional analysis of CfSnf1 in the development and pathogenicity of anthracnose fungus Colletotrichum fructicola on tea-oil tree. BMC Genet. 2019, 20, 94. [Google Scholar] [CrossRef] [PubMed]
- Hemetsberger, C.; Herrberger, C.; Zechmann, B.; Hillmer, M.; Doehlemann, G. The Ustilago maydis effector Pep1 suppresses plant immunity by inhibition of host peroxidase activity. PLoS Pathog. 2012, 8, e1002684. [Google Scholar] [CrossRef]
- Nakatogawa, H.; Ichimura, Y.; Ohsumi, Y. Atg8, a ubiquitin-like protein required for autophagosome formation, mediates membrane tethering and hemifusion. Cell 2007, 130, 165–178. [Google Scholar] [CrossRef] [PubMed]
- Klionsky, D.J. For the last time, it is GFP-Atg8, not Atg8-GFP (and the same goes for LC3). Autophagy 2011, 7, 1093–1094. [Google Scholar] [CrossRef]
- Fukada, F.; Kodama, S.; Nishiuchi, T.; Kajikawa, N.; Kubo, Y. Plant pathogenic fungi Colletotrichum and Magnaporthe share a common G(1) phase monitoring strategy for proper appressorium development. New Phytol. 2019, 222, 1909–1923. [Google Scholar] [CrossRef]
- Fukada, F.; Kubo, Y. Colletotrichum orbiculare Regulates Cell Cycle G1/S Progression via a Two-Component GAP and a GTPase to Establish Plant Infection. Plant Cell 2015, 27, 2530–2544. [Google Scholar] [CrossRef] [PubMed]
- Ryder, L.S.; Cruz-Mireles, N.; Molinari, C.; Eisermann, I.; Eseola, A.B.; Talbot, N.J. The appressorium at a glance. J. Cell Sci. 2022, 135, jcs259857. [Google Scholar] [CrossRef]
- Levin, D.E. Regulation of cell wall biogenesis in Saccharomyces cerevisiae: The cell wall integrity signaling pathway. Genetics 2011, 189, 1145–1175. [Google Scholar] [CrossRef]
- Malavazi, I.; Goldman, G.H.; Brown, N.A. The importance of connections between the cell wall integrity pathway and the unfolded protein response in filamentous fungi. Brief Funct. Genom. 2014, 13, 456–470. [Google Scholar] [CrossRef]
- Liu, X.; Zhou, Q.; Guo, Z.; Liu, P.; Shen, L.; Chai, N.; Qian, B.; Cai, Y.; Wang, W.; Yin, Z.; et al. A self-balancing circuit centered on MoOsm1 kinase governs adaptive responses to host-derived ROS in Magnaporthe oryzae. Elife 2020, 9, e61605. [Google Scholar] [CrossRef] [PubMed]
- Scherz-Shouval, R.; Elazar, Z. Regulation of autophagy by ROS: Physiology and pathology. Trends Biochem. Sci. 2011, 36, 30–38. [Google Scholar] [CrossRef] [PubMed]
- Zhou, J.; Li, X.Y.; Liu, Y.J.; Feng, J.; Wu, Y.; Shen, H.M.; Lu, G.D. Full-coverage regulations of autophagy by ROS: From induction to maturation. Autophagy 2022, 18, 1240–1255. [Google Scholar] [CrossRef] [PubMed]
- Wang, J.; Qi, Q.; Zhou, W.; Feng, Z.; Huang, B.; Chen, A.; Zhang, D.; Li, W.; Zhang, Q.; Jiang, Z.; et al. Inhibition of glioma growth by flavokawain B is mediated through endoplasmic reticulum stress induced autophagy. Autophagy 2018, 14, 2007–2022. [Google Scholar] [CrossRef]
Disclaimer/Publisher’s Note: The statements, opinions and data contained in all publications are solely those of the individual author(s) and contributor(s) and not of MDPI and/or the editor(s). MDPI and/or the editor(s) disclaim responsibility for any injury to people or property resulting from any ideas, methods, instructions or products referred to in the content. |
© 2023 by the authors. Licensee MDPI, Basel, Switzerland. This article is an open access article distributed under the terms and conditions of the Creative Commons Attribution (CC BY) license (https://creativecommons.org/licenses/by/4.0/).







